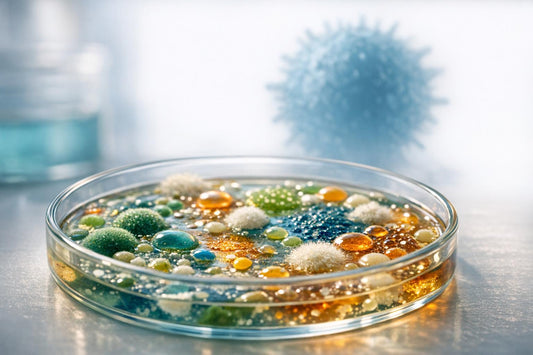
T-Cell Differentiation: Role of Microbial Metabolites

News

Synbiotics and Metabolic Health: Clinical Insights
Synbiotics combine probiotics (live bacteria) and prebiotics (fiber that feeds good bacteria) to improve gut health and metabolic functions. Research highlights their role in reducing blood sugar, aiding weight loss,...
Synbiotics and Metabolic Health: Clinical Insights
Synbiotics combine probiotics (live bacteria) and prebiotics (fiber that feeds good bacteria) to improve gut health and metabolic functions. Research highlights their role in reducing blood sugar, aiding weight loss,...

Gut Microbiome and Sleep: What Science Says
Your gut health and sleep are deeply connected. The gut-brain axis - a communication network between your gut and brain - plays a key role in regulating sleep. When your...
Gut Microbiome and Sleep: What Science Says
Your gut health and sleep are deeply connected. The gut-brain axis - a communication network between your gut and brain - plays a key role in regulating sleep. When your...

How Postbiotics Help Restore Gut-Immune Balance
Your gut health directly impacts your immune system - 70% to 80% of immune cells reside in your gut. When this balance is disrupted, it can lead to chronic inflammation,...
How Postbiotics Help Restore Gut-Immune Balance
Your gut health directly impacts your immune system - 70% to 80% of immune cells reside in your gut. When this balance is disrupted, it can lead to chronic inflammation,...

Human-Origin Probiotics for Peak Performance
Human-origin probiotics - microbes sourced directly from humans - are gaining attention for their potential to boost athletic performance, recovery, and immunity. Unlike food- or soil-based probiotics, these strains are...
Human-Origin Probiotics for Peak Performance
Human-origin probiotics - microbes sourced directly from humans - are gaining attention for their potential to boost athletic performance, recovery, and immunity. Unlike food- or soil-based probiotics, these strains are...

C-Section and Gut Health: Role of Synbiotics
C-section births can disrupt gut bacteria development, increasing risks for issues like obesity, asthma, and allergies. Synbiotics - a mix of probiotics and prebiotics - can help restore gut balance...
C-Section and Gut Health: Role of Synbiotics
C-section births can disrupt gut bacteria development, increasing risks for issues like obesity, asthma, and allergies. Synbiotics - a mix of probiotics and prebiotics - can help restore gut balance...
T-Cell Differentiation: Role of Microbial Metab...
T cells are a core part of your immune system, and their ability to adapt depends heavily on signals from your gut microbiota. These signals come in the form of...
T-Cell Differentiation: Role of Microbial Metab...
T cells are a core part of your immune system, and their ability to adapt depends heavily on signals from your gut microbiota. These signals come in the form of...
